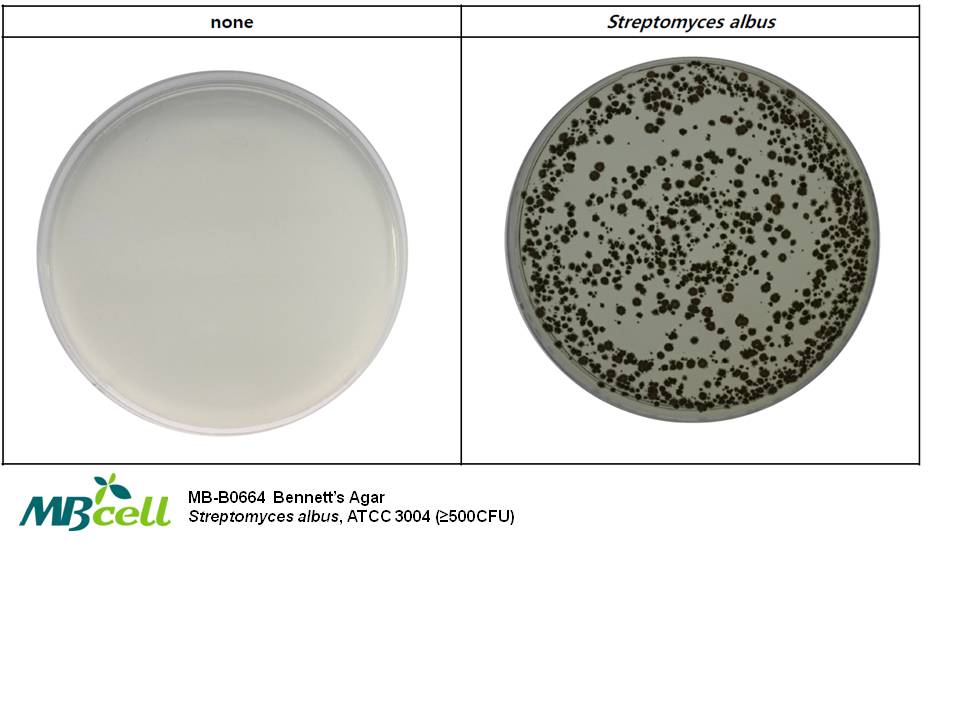

SKU : MB-M0664
หมวดหมู่ : 12. Lab Equipment ,  MB Cell , 
แบรนด์ : MB cell
Share
Bennett's Agar [MB-B0664]
Medium used for the isolation and cultivation of Actinomycetes spp.
PROCEDURE
Suspend 29.0 G in 1 L of distilled or deionized water. Heat to boiling until completely dissolved. If necessary, adjust the pH 7.3 ± 0.2. Heat to boiling until completely dissolved. Sterilize by autoclave at 121°C for 15 minutes. Cool to 45 - 50°C in water bath. If necessary, aseptically add 2 vials of Bennett’s supplement (MB-B0755) for the isolation of Actinomycetes spp. Mix well. Pour into petri dishes.
STORE
The powder is very hygroscopic. Store the powder at room temperature, in a dry environment, in its original container tightly closed and use it before the expiry date on the label or until signs of deterioration or contamination are evident. Store prepared medium at 2 - 8°C.